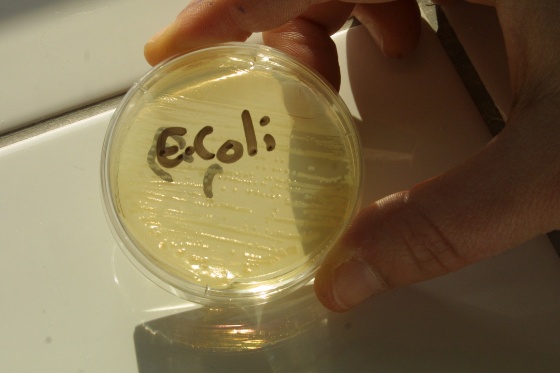
ecoli.jpg (Bredde: 560px)

E.coli til besvær
Utbruddet av sykdomsfremkallende E.coli i Europa er en påminnelse om at matvarehygiene må tas seriøst, og at feil i jakten på smittekilder kan få enorme økonomiske konsekvenser, skriver Ørjan Olsvik i denne kronikken.
![]() |
|
E. coli bakterien forekommer naturlig i tarmen og er vanligvis helt ufarlig. Men det hender at den henter sykdomsfremkallende egenskaper fra andre bakterier, for eksempel kolera- eller dysenteribakterier. Illustrasjonsfoto: www.colourbox.com |
Av Ørjan Olsvik, professor i medisinsk mikrobiologi ved Det helsevitenskapelige fakultet, UiT.
![]() |
E. coli bakterien hører naturlig hjemme i tarmen til friske mennesker. Når bakterien får nye egenskaper og slår seg vrang kan det forårsake alvorlig sykdom hos vertskapet.
Utbruddet av blodig diare med nyresvikt og død i mai/juni 2011 i Europa, er en god påminnelse om at matvarehygiene må tas seriøst, og at feil i jakten på smittekilder kan få enorme økonomiske konsekvenser.
I 1885 fant den østeriske professor og barnelege Theodor Escherich en bakterie i avføringen på barn med diaré som han ga navnet Bacterium commune comma; den bakterien som er vanlig og ser ut som et komma. Det ble snart god latin at denne bakterien var ufarlig og fantes i tarmen hos alle mennesker og varmblodige dyr. Professor Escherich døde i 1911 og fikk bakterien oppkalt etter seg; Escherichia coli, eller som vi vanligvis kjenner den: E. coli.
Spiller på andre bakterier
Men bakterien ble oftere og oftere funnet hos syke pasienter, og det syntes klart E. coli kunne være både ufarlig og sykdomsfremkallende. Det viste seg nemlig at arten E. coli var ekspert i å hente sykdomsfremkallende egenskaper fra andre bakterier. Flere typer E. coli ble etterhvert funnet og de er nå blant de vanligste årsakene til urinvegsinfeksjoner, særlig hos kvinner, blodforgiftninger og diaré. Til tross for dette er E. coli en normal og ufarlig, ja gjerne nødvendig bakterie i vårt fordøyelsessystem, og de fleste av oss har milliarder av ufarlige E. coli bakterier i tarmen.
Enkelte E. coli har klart å ta opp egenskaper fra kolerabakterien og kan derfor produsere et giftstoff som gir kraftig diaré. Denne typen E. coli er årsak til det mange oppfatter som turist diaré, men den fører også til nærmere 500.000 diaré dødsfall årlig blant barn under 5 år i utviklingsland.
“Hamburgerbakterien”
I 1982 ble det funnet en ny og hittil ukjent E. coli hos to pasienter fra statene Michigan og Oregon i USA. Felles for disse to var sterke magesmerter og blodig diaré, og at begge hadde spist dårlig stekte hamburgere. Det viste seg at denne nye E.coli varianten hadde klart å ta opp egenskaper fra dysenteribakterien og kunne nå produsere svært kraftig giftstoffer som ødela tarmoverflaten. Bakterien fikk på folkemunne navnet “hamburgerbakterien”. Noen pasienter fikk i tillegg også blod i urinen etter ca 1 uke. Giftstoffet fra bakterien hadde nemlig angrepet og ødelagt nyrene, mange pasienter døde. Denne nye varianten av bakterien fikk navnet enterohemorrhagiske E. coli, i dag kanskje bedre kjent som EHEC.
Flere store “hamburger-utbrudd” kom i USA og Canada, men alvorligheten kom tydelig frem ved et utbrudd i et sykehjem i Ontario i 1985. Her ble 32% av beboerne smittet, og 31% av disse døde. Kilden syntes å være en syk kokk. Utbruddet av EHEC i Japan i 1999 er kanskje hittil det største; 12680 personer ble syke etter å ha spist reddiker, men kun 121 fikk nyresykdom og heldigvis døde bare 3 pasienter.
Usedvanlig smittsom
Disse nye E. coli variantene noe av de mest smittsomme bakterier vi kjenner. Det trengs fra 100.000 til 1 million kolerabakterier for å få sykdom; 1-100 EHEC-bakterier er ofte nok til å gi alvorlig blodig diaré.
For mange ble “kjøttdeig-utbruddet” i Norge i 2006 det første møte med EHEC gjennom en intens media-dekning. Her ble til sammen 18 personer, hvorav 16 barn, syke etter å ha blitt smittet av E. coli over en 8 ukers periode. Ett av barna døde. Smittekilden viste seg til slutt å være morrpølse.
Svært agressiv
Utbruddet av E. coli med blodig diaré i mai/juni 2011 i Tyskland med forgreininger til flere Europeiske land er av de største og kanskje farligste vi har sett. Pr. 8. juni er flere enn 2.500 pasienter påvist med sykdom, hvorav minst 650 fått nyresykdom og 24 har dødd. Dette er meget alarmerende siden en usedvanlig høy andel av pasientene har fått nyresykdom og antall døde er meget stort. Spesielt er det også at eldre og barn ikke er spesielt angrepet, det er derimot kvinner. Denne spesielle EHEC- bakterien er også motstandsdyktig mot antibiotika, men det er forholdsvis uvesentlig. Disse pasientene ikke skal behandles med antibiotika, da dette kan frigjøre mer giftstoffer fra bakterien.
Jakten på smittekilden
Varmblodige dyr, spesielt friske storfe og småfe synes å være kilde for disse EHEC- bakteriene, og spredningen skjer i hovedsak via dyrenes avføring. Gjerne som gjødsel til grønnsaker, smitte til kjøttprodukter, og vann som er forurenset med dyreavføring. Nye tilfeller i slutten av et utbrudd er gjerne forårsaket av smitte fra syke til friske mennesker.
Kilden ble først antatt å være spanske agurker, men det genetiske fingeravtrykk av disse bakteriene stemte ikke med utbruddsbakterien funnet hos pasientene, og agurkene ble frikjent. Deretter ble bønnespirer fra Tyskland annonsert som kilden og dagen etter like raskt frikjent. Det er et vitenskapelig kommunikasjonsproblem at preliminære data som ikke holder mål blir brukt til å lansere nye “smittekilder”. Tyskland og Spania diskuterer nå mulige erstatninger på mange milliarder kroner de som har lidd store tap grunnet “agurk-sporet”.
Alle E. coli er ikke ufarlige
Utbruddet av enterohemorrhagiske E. coli i sommer viser at E. coli er mer enn E. coli; de aller fleste E. coli er normale og ufarlige og lever et godt liv i symbiose med oss inne i vårt tarmsystem, men det finnes altså E. coli varianter som har plukket opp egenskaper som skal til for å gi sykdommer hos mennesker.